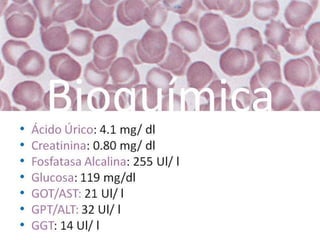
Bioquímica• Ácido Úrico: 4.1 mg/ dl
• Creatinina: 0.80 mg/ dl
• Fosfatasa Alcalina: 255 Ul/ l
• Glucosa: 119 mg/dl
• GOT/AST: 21 Ul/ l
• GPT/ALT: 32 Ul/ l
• GGT: 14 Ul/ l

La anemia es una enfermedad hemática caracterizada por una disminución de la masa eritrocitaria y hemoglobina, presentando diversos tipos según las causas. En el caso de una mujer de 60 años, se identifica una anemia normocítica hipocrómica probablemente secundaria a cáncer de colon, evidenciada por niveles bajos de hemoglobina, hematocrito y ferritina. Los síntomas como astenia y palidez cutánea reflejan un déficit en el transporte de oxígeno a los tejidos, lo que agrava su condición.